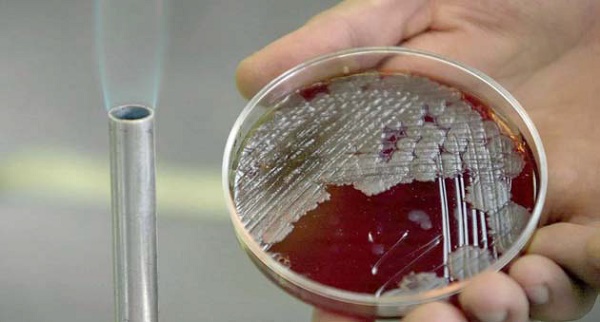

عاجل
- الرئيس السيسى يجدد الدعوةللرئيس التونسى للمشاركة بافتتاح المتحف الكبير
- الرئيس السيسي يوجه بترسيخ دور مصر كمركز إقليمي للطاقة في شرق المتوسط
- تفاصيل زيارة وفد وزارة التعليم لمحافظة المنوفية
- رئيس الوزراء يستقبل نظيرته التونسية بمطار القاهرة الدولي
- وزير الإسكان يترأس اجتماع اللجنة التنسيقية العليا لمتابعة العمل بالمدن